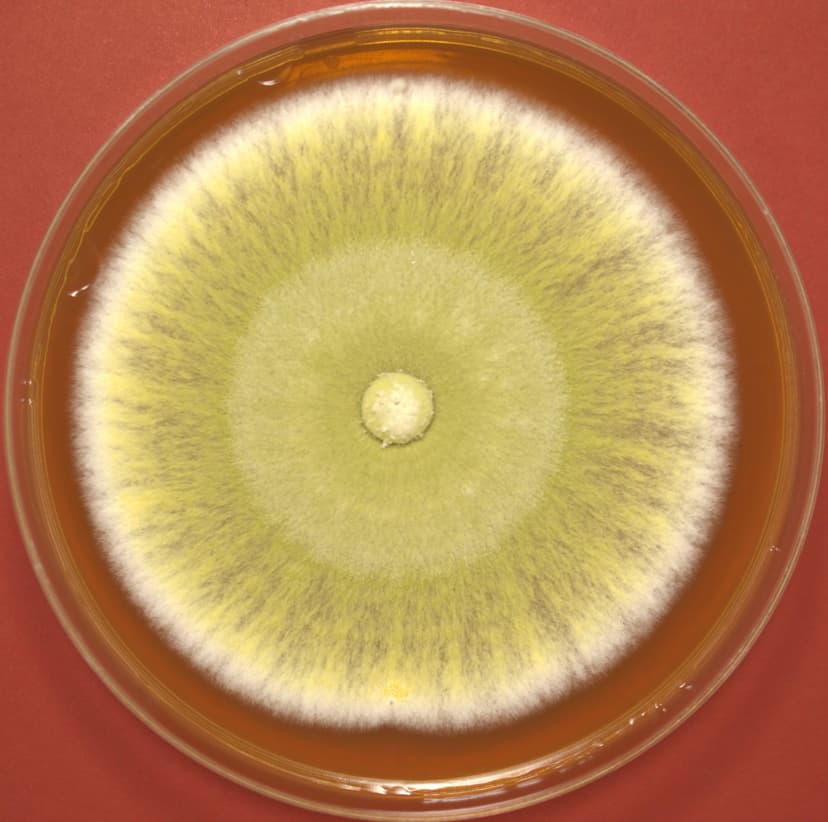

This work aims to develop strategies to increase the production and resilience of maize to climate change, using native beneficial fungi, promoting a sustainable agricultural system that can be expanded to other crops in Colombia and Argentina.
Native fungal biodiversity in promoting positive effects on maize agroecosystems
.jpg&w=3840&q=100)
"If no actions are taken to mitigate the effects of climate change, it is estimated that by 2030 there will be a significant reduction in the areas suitable for maize production, as well as a decrease in crop productivity by up to 30 %."— Gómez et al., 2019. Maize for Colombia. Vision 2030
.jpg&w=3840&q=100)